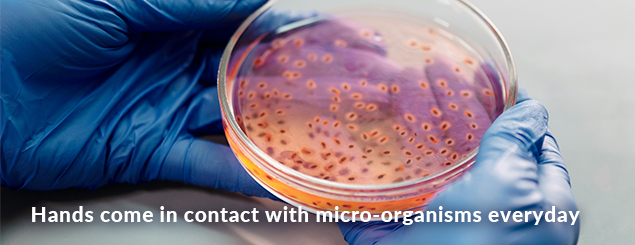
Bacteria
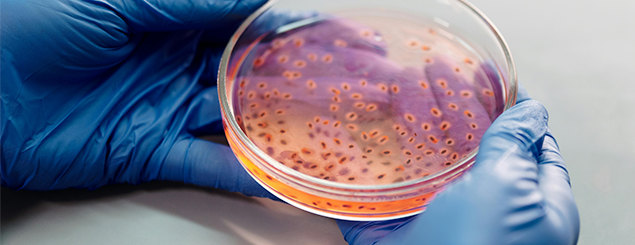

Empowering Disposable Glove Users
For A Better Tommorrow
There are 1000's of disposable glove variations on the market and much at stake.
Disposable gloves are the front-line barrier to illnesses that can be life threatening, chemical interactions that can scar or damage health for years to come, and the spread of infectious elements to customers, family and friends.
Disposable gloves are not a fashion statement or mark of a profession, but tools to protect people from illness and chemical harm, to keep materials clean and safe, and to make messy jobs easier.
Our vision is a future where proactive measures in educating consumers about the advantages of using sustainable protective disposable glove will contribute significantly to lowering public health risks, enhancing user safety, and preventing unnecessary illness burden worldwide.

Most Important Things
When it comes to disposable glove safety, here are the most important points to consider: LEARN MORE
When It's Fit To Use
To determine when a disposable glove is not fit for use, look for the following signs: Learn More
Glove Failure Rates
Glove failure rates can vary based on several factors, including the type of glove: LEARN MORE
Cross-Contamination
Occuring particularly in healthcare, food handling, and laboratories: LEARN MORE